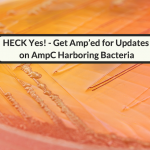

In this article an infectious diseases physician discusses antibiotic card games and game-based learning. Authored By: Scott Crabtree, M.D., MPH Article Posted 7 March 2022 Educational games are increasing in popularity and demand. Antibiotic card games like Empiric, Healing Blade: Defenders of Soma, and the Pharmageddon: Bugs vs Drugs are the … [Read more...]
A Pain In The Acinetobacter: 5 Key Challenges For Treating Carbapenem-Resistant Acinetobacter baumannii Infections
In this article five key challenges for treating carbapenem-resistant Acinetobacter baumannii are discussed. Authored By: Bessma Hassani, PharmD, BCPS Mentored By: Debra Willner, Pharm.D., BCIDP Article Posted: 12 February 2022 Acinetobacter baumannii is a major cause of nosocomial infections worldwide. It is one of the most common pathogens … [Read more...]
HECK Yes! Get Amp’ed For Updates On AmpC Harboring Bacteria
In this article inducible drug resistance in AmpC harboring bacteria are discussed using the acronym HECK Yes. Authored by: Brandon Garcia, Pharm.D. Article Mentor: Madeline King, Pharm.D., BCIDP Article Posted 25 January 2022 AmpC β-lactamases are Ambler class C enzymes that can be divided into three categories: (1) inducible resistance (e.g., Enterobacter … [Read more...]
Critical Social Factors For Antimicrobial Stewardship: A Focus On Pride
In this article an infectious diseases pharmacist discusses pride and antimicrobial stewardship. Authored By: Timothy P. Gauthier, Pharm.D., BCPS, BCIDP Article Posted: 8 January 2022 The Oxford Dictionary defines pride as a feeling of deep pleasure or satisfaction derived from one's own achievements, the achievements of those with whom one is closely … [Read more...]
Sesame Street Songs & Fundamental Lessons For Antibiotic Prescribing
In this light-hearted article fundamental lessons from Sesame Street songs are applied to the field of antimicrobial stewardship. Authored By: Timothy P. Gauthier, Pharm.D., BCPS, BCIDP Article Posted 2 January 2022 As a father of two I have spent my fair share of time watching the children's show Sesame Street on television. When compared to many of … [Read more...]